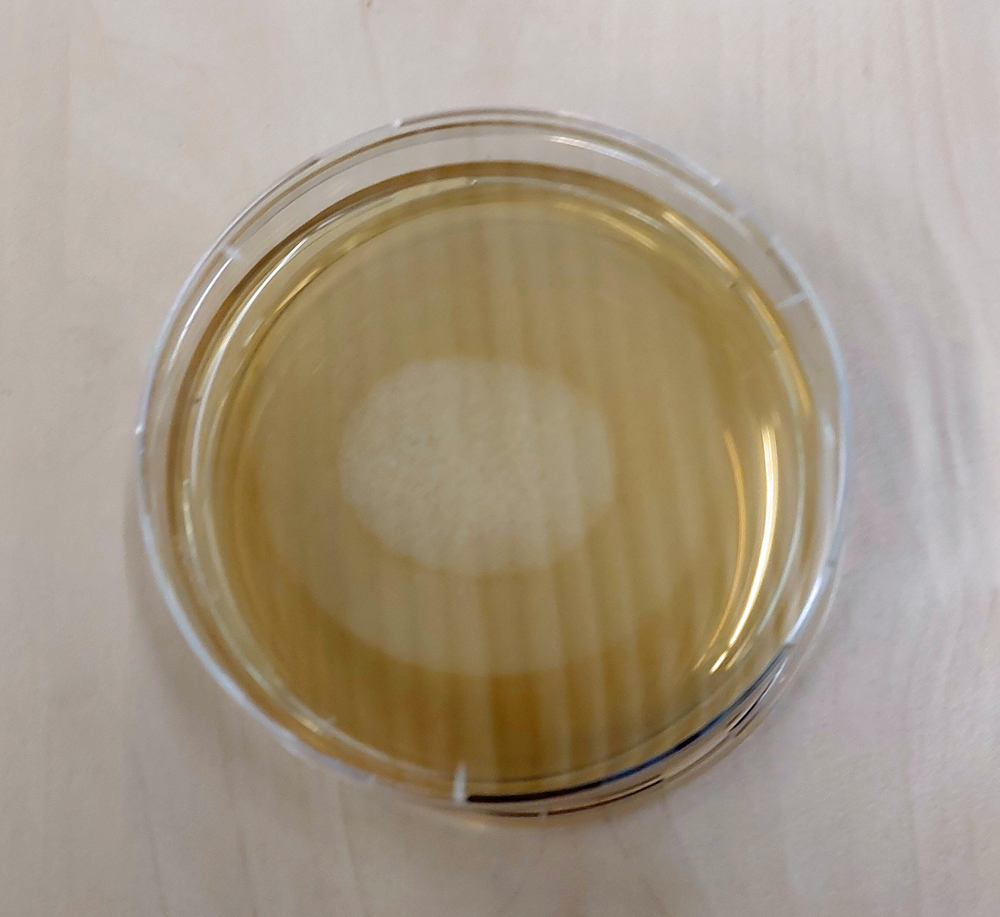

Gestern, am 18. Mai startete vom Gelände der Gießener Universität ein Helium-Ballon mit mehreren Experimenten aus dem Bereich der Physik und der Biologie, die Ergebnisse des Einflusses der Stratosphäre (ca. 35 km Höhe) bringen sollen.

Beteiligte sind StudentInnen, Studenten und Mitarbeiter des II. Physikalischen Institutes sowie ein Amateurfunker.
Von Seiten der Physik sind Experimente mit Strahlungsmesstechnik an Bord, von Seiten der Biologie geht es um Bakterien und Sporen. Natürlich fährt auch eine Kamera mit. Über die einzelnen Versuche und die daran Beteiligten wird an dieser Stelle noch ausführlich berichtet werden. Einige Daten (vor allem die Positions-Daten) werden während des Fluges über einen „Tracker“ mit Handy-Technik und mit einem Positions-Sender mit Amateurfunktechnik realisiert. Hier ist unser Redakteur Winfried Senger mit seiner Amateurfunk-LIzenz mit dabei. Die vollständigen Daten der Experimente werden auf einer Speicherkarte festgehalten.

Zunächst gibt es Startvorbereitungen, dann folgt der Start.

Das Spannende nach dem Start: Wohin wird der Ballon getrieben, und wo wird der Ballon nach dem Platzen in 35 km Höhe und nach dem einstündigen Sinkflug wiedergefunden?
Wie bei jedem Experiment dieser Art ist das Wiederauffinden des Ballons nicht gesichert. Die Dauer des Gesamtfluges wurde auf etwa 3 Stunden geschätzt: 2 Stunden Aufstieg und eine Stunde Sinken an einem Fallschirm. Die Windrichtung in den verschiedenen Höhen spielt dabei die entscheidende Rolle. Und so waren nach dem Start und nach dem Platzen des Ballons viele Augen auf das Funk-Gerät gerichtet, das die GPS-Daten des Ballons übertrug. Ein Fahrzeug war anschließend unterwegs, um die Rückkehr des Ballons zu beobachten, zu verfolgen und den Ballon zu finden.
Doch dann trat das ein, was nicht passieren sollte. Etwa eine Stunde nach dem Start endete die Funk-Übertragung der Sonde, was auch erwartet worden war. Doch nach dem Platzen des Ballons sollten sowohl der Tracker als auch das Funkgerät wieder Kontakt zum Ballon bekommen.
Doch diese Kontakte kamen nicht zustande..
Um 16:26 Uhr, nach mehr als 4 Stunden, folgte ein Status-Update: Der Ballon ist verschollen !
Da bleibt nur die Hoffnung, dass jemand den Ballon findet und sich bei den Eigentümern meldet. Über den Hessischen Rundfunk und FFH soll ebenfalls Hilfe bei der Ballonsuche gebeten werden. Auch wenn jemand unserer Leser den Ballon gesichtet hatte: Bitte melden.
Was auf jedenfall bei den Akteuren bleibt, ist die Freude beim Aufbau der Experimente, ein spannender Start und wieder ein Mehr an Erfahrung. Dies bleibt den Beteiligten erhalten, auch wenn der Ballon im Augenblick „verschollen“ ist.
Fotos und Video: Winfried Senger
